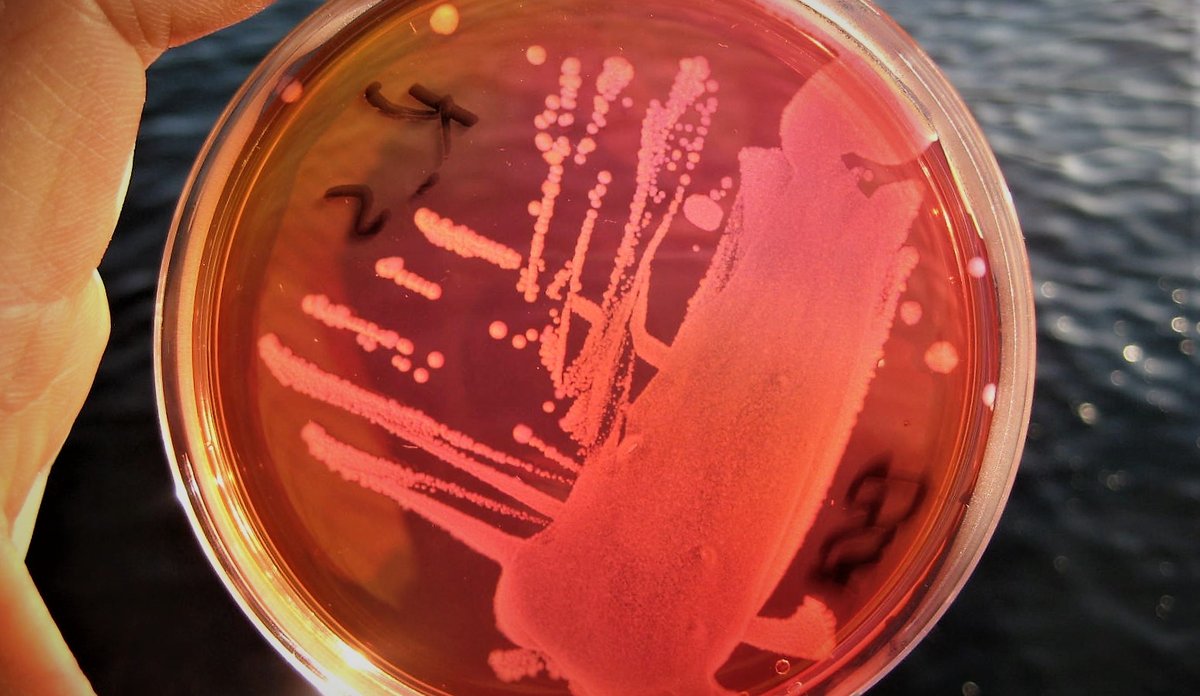
test

Vibrio-bakteriar har sjø- og brakkvatn som sitt naturlege leveområde. Vibrio-slekta inneheld om lag 140 kjende arter. Mellom desse kan over 20 artar gje sjukdom hos dyr, medan 12 kan gje sjukdom hos menneske.
Publisert: 17.09.2019
Oppdatert: 04.06.2024
Vibrio kan gje sjukdom
Kor vanlege dei artane som kan gje sjukdom er, er sterkt avhengig av temperatur, og dei er å finna i høgast konsentrasjon når temperaturen i vatnet kjem over 18 grader i ein lengre periode.
Dei vanlegaste artane knytt til sjukdom er Vibrio parahaemolyticus, V. alginolyticus, V. vulnificus og V. cholerae. Desse kan gje sjukdom omtala som vibriose, og inkluderer infeksjonar i mage og tarm etter at ein har ete mat med Vibrio-bakteriar, eller infeksjonar i opne sår eller i øyrene etter at ein har vore utsett for slike bakteriar når ein badar. Folkehelseinstituttet (FHI) har ansvar for å gje råd om vibrioinfeksjonar og om korleis ein kan beskytte seg (Bakterier i sjøvann kan gi infeksjoner - FHI). FHI overvaker også fortløpande talet på registrerte infeksjonar (MSIS Statistikk - Folkehelseinstituttet).
Er å finna naturleg
Vibrio-bakteriar finn ein naturleg i det marine miljøet, og dei trivst godt i område langs kysten der saltkonsentrasjonane er lågare. Vibrio veks særs godt når temperaturen aukar, og vasstemperaturen er difor ein viktig faktor for å kunne seie noko om mogleg Vibrio-oppblomstring. Men i tillegg til temperatur, er det andre faktorar som kan påverke oppblomstring. Vibrio har blant anna svært kort generasjonstid (delingstid), og under optimale forhold kan dei doble seg kvart 10. minutt. For at dette skal skje, må dei ha tilstrekkeleg næring som karbon, nitrogen og fosfor. Auka næringssalt i kystvatnet grunna utslepp og avrenning frå land vil derfor også kunne påverke oppblomstring. Enkelte stader i verda har ein òg sett samanheng mellom algeoppblomstring med etterføgljande oppblomstring av Vibrio og auka registrerte tilfelle av vibriose. I tillegg vil vêrforhold og kyststraumar kunne påverke utbreiing av ei Vibrio-oppblomstring.
Vibrio er vanskeleg å overvake
Havforskingsinstituttet har funne Vibrio i sjøvatn, skaldyr, fisk og sediment i Noreg. Men sidan det ikkje er fastsett internasjonale grenseverdiar og at Noreg dermed ikkje har noko etablert overvakingsprogram for Vibrio, finst det begrensa med data på dette. I dei fleste undersøkte tilfella har ikkje bakteriane frå våre havområde dei genane som skal til for å gje sjukdom (virulensgener). Det er derfor krevjande å finne ein god metode for å overvake for Vibrio. Funn av Vibrio i sjøvatn vil ikkje nødvendigvis betyr at staden ikkje er trygg, og heller ikkje fråvær av funn vil kunne seie at det er trygt.
Det er heller ingen samanheng mellom Vibrio og forureining med tarmbakteriar, og tradisjonelle testar for kloakkureining gir derfor ikkje informasjon om potensielt sjukdomsframkallande Vibrio-bakteriar.
Vibrio i sjømat
Vibrio kan leve på og i sjømatorganismar. Sjømaten kan derfor naturleg inneha Vibrio-bakteriar. Desse bakteriane har låg toleranse for varmehandsaming, frysing, tørking og andre konserveringsmetodar, men mat som vert eten rå eller etter lett varmehandsaming utgjer ein større risiko, som til dømes østers. Alle matprodusentar må kunne dokumentere sal av trygge sjømatprodukt. Dersom ein fiskar fisk eller sankar skjel sjølv, vil varmehandsaming vere eit godt tiltak for å sikre trygg mat.
Sjømat frå område med varmare temperaturar kan ha hyppigare førekomst av Vibrio med virulensgener. På oppdrag for Mattilsynet overvakar derfor Havforskingsinstituttet Vibrio i importert sjømat (Veterinær grensekontroll - Import av animalske varer fra tredjestat | Mattilsynet).
Vibrio og klimaendringar
Temperaturen i havet er ein viktig faktor for vekst av Vibrio. Endringar i klima vil kunne gje hyppigare oppblomstringar når vasstemperaturane aukar over lengre tid. Då det var marin hetebølge i 2018, auka talet på registrerte tilfelle av vibriose. Då det ikkje finst data på førekomst av Vibrio langs kysten frå 2018 eller andre år, er det uklårt kor og når oppblomstringa starta og kor lenge den varte.
Klimamodellar baserte på dagens utslepp viser at havtemperaturen vil kunne auke med 1–4 °C og at auka nedbør vil kunne redusere saltkonsentrasjonen og gjere kystvatnet ferskare. Dette vil truleg gjere forholda i havet meir gunstig for oppblomstring av Vibrio.
Antibiotikaresistente Vibrio
Fordi Vibrio-bakteriar kan finnast naturleg i havmiljøet og samstundes kan ta til seg resistenseigenskapar, kan dei brukast til å overvaka spreiing og utvikling av antibiotikaresistens i miljøet. Sjølv om det er eit relativt lågt forbruk av antibiotika i Noreg, kan både antibiotika og resistente bakteriar nå havmiljøet via kloakk og avrenning frå land. Overvaking av resistens blant Vibrio kan derfor fungere som ei viktig brikke for å følgje med på antibiotikaresistens i havet.
Nøkkeldata
- Gram-negativ stavbakterie
- 140 kjente artar
- Fakultativt anaerob vekst (med/utan oksygen)
- Veks ved 10–44 °C (avhengig av art)
- Toler frysing og varmehandsaming dårleg
- Kan veksa ved pH 4–10
- Kan veksa ved opptil 8 % salt i mediet (nokre artar)
- Tolv artar vert rekna som humanpatogene: V. cholerae, V. parahaemolyticus, V. vulnificus, V. fluvialis, V. alginolyticus, V. damsela, V. furnissii, V. hollisae, V. mimicus, V. cincinnatiensis, V. metschnikovii, V. carchariae.